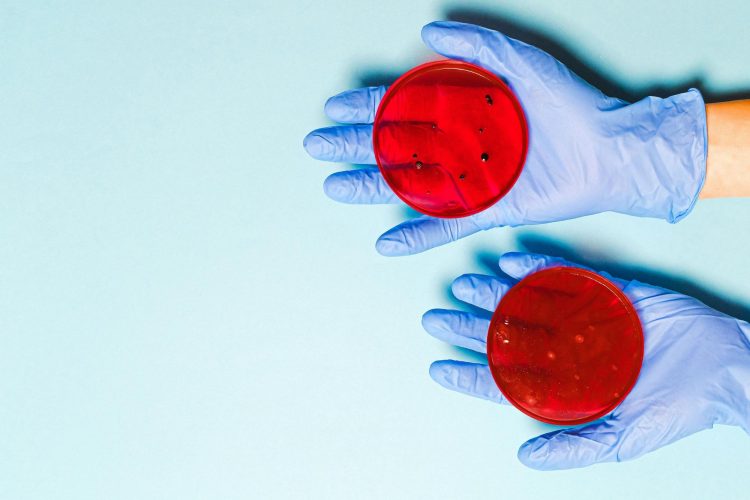
Κλινικές μελέτες σήμερα

Μονόδρομος για την δωρεάν πρόσβαση ασθενών σε καινοτόμες θεραπείες. Η Ελλάδα μπορεί να προσελκύσει επενδύσεις πάνω από 500 εκ. σε ετήσια βάση, γεγονός που θα εκτόξευε το ΑΕΠ κατά 1 δις, η χώρα θα κέρδιζε από φόρους 180 εκ. έσοδα και θα άνοιγαν 23.000 θέσεις εργασίας.
Γράφει Η Νανά Παλαιτσάκη
Συναντήσεις εργασίας με εκπροσώπους του τύπου, πραγματοποίησε ο σύλλογος HACRO ( Contract Research Organization) . O HACRO αποτελεί τον θεσμικό φορέα των Κατ’ Ανάθεση Οργανισμών Έρευνας – CRO’s των εταιρειών εκείνων που διαθέτουν τεχνογνωσία και εξειδίκευση για τον σχεδιασμό, διαχείριση, παρακολούθηση και ποιοτική διεξαγωγή των κλινικών μελετών όλων των τύπων και των φάσεων στην Ελλάδα .
Σκοπός των συναντήσεων η ενημέρωση των δημοσιογράφων του ιατρικού ρεπορτάζ για τις εξελίξεις που αφορούν στις κλινικές μελέτες, την θέση της Ευρώπης, η οποία προσπαθεί ν’ ανακτήσει την χαμένη αίγλη της στον τομέα αυτό, καθώς Αμερική και Κίνα, φαίνεται να διεκδικούν την «μερίδα του λέοντος» και η θέση της Ελλάδας, η οποία θα μπορούσε να έχει ετησίως 500 εκ έσοδα από την διεξαγωγή των κλινικών μελετών.
Όμως μόλις το 1,7% των κλινικών μελετών που έγιναν στην Ευρώπη την 20ετία 2000-2020, πραγματοποιήθηκαν στην Ελλάδα.
Στην Ευρώπη έχουν διεξαχθεί μέσα στα 20 χρόνια 4000 μελέτες ενώ στην χώρα μας το ίδιο διάστημα έγιναν μόλις 3.101 !
Ποιοι είναι οι μεγάλοι χαμένοι από την καθυστέρηση ανάπτυξης των κλινικών μελετών στην Ελλάδα ;
Οι ασθενείς, το σύστημα Υγείας, η οικονομία .
Η Ελλάδα αναλογικά θα μπορούσε σε ετήσια βάση να έχει έσοδα από κλινικές μελέτες της τάξης των 500 εκατ. Ευρώ σ’ ένα περιβάλλον όπου για Έρευνα και Ανάπτυξη νέων φαρμάκων διατίθενται 50 δις τον χρόνο, η θέση της χώρας μας στον τομέα αυτό, μπορεί να συμπορευτεί με την επιδίωξη των υπόλοιπων χωρών της Ευρώπης ν’ ανακτήσουν την χαμένη ανταγωνιστικότητά τους και να προσελκύσουν παγκόσμιες επενδύσεις. Από τον Ιανουάριο του 2025 ο νέος Ευρωπαϊκός Κανονισμός και το νέο, ενιαίο Πληροφοριακό Σύστημα Κλινικών Δοκιμών της ΕΕ (CTIS), όπου όλες οι κλινικές μελέτες που πραγματοποιούνται στην Ευρώπη θα βρίσκονται στην ίδια πληροφοριακή πλατφόρμα και θα φαίνεται η πορεία τους από χώρα σε χώρα.
Για την προσέλκυση όμως των ανάλογων επενδύσεων από τη χώρα μας, χρειάζεται επιτάχυνση των διαδικασιών έγκρισης προκειμένου η Ελλάδα να είναι ελκυστική, καθώς η τήρηση των χρονοδιαγραμμάτων είναι εξαιρετικά σημαντικός παράγοντας για την επιλογή των ερευνητικών κέντρων και χωρών.
Οι χορηγοί ενδιαφέρονται να εντάξουν την χώρα στο ευρωπαϊκό πλάνο επενδύσεων, η πορεία των κλινικών μελετών το τελευταίο χρονικό διάστημα είναι ανοδική, αλλά θα μπορούσαν όλα να είναι πολύ καλύτερα αν υπήρχε διαρκής πολιτική βούληση στον τομέα αυτό, καθώς η άσκοπη γραφειοκρατία ,οι δομικές ελλείψεις στο σύστημα υγείας , η έλλειψη ενημέρωσης των εμπλεκομένων αποτρέπουν τις επενδύσεις στην κλινική έρευνα.
Στις αλλαγές που έρχονται στην Ευρώπη στον τομέα έρευνας και ειδικότερα αυτόν των κλινικών μελετών, αναφέρθηκε η πρόεδρος του Συλλόγου Επιχειρήσεων Διεξαγωγής Κλινικών Μελετών HACRO κ. Ευαγγελία Κοράκη ,στην οποία συμμετείχαν επίσης τα μέλη του Δ.Σ.: Νίκος Κωστάρας, Αντιπρόεδρο, Κατερίνα Μαντοπούλου, Γραμματέας, Χρήστος Ίσκος Ταμίας και Σπύρος Αναγνωστόπουλος, Μέλος Δ.Σ.
Η κ. Κοράκη επεσήμανε ότι την τελευταία πενταετία, οι δείκτες παρουσίασαν σαφή βελτίωση και αυξήθηκαν κατά 70%, με 262 εγκεκριμένες για φάρμακα και ιατροτεχνολογικά το 2022 έναντι 154 το 2019.
Θετικότερο κλίμα
Πέρυσι, καταγράφηκε αριθμός ρεκόρ υποβολών που έφτασαν τις 320 αιτήσεις για έγκριση νέων κλινικών μελετών, οι 298 αφορούσαν φάρμακο και οι 22 ιατροτεχνολογικά προϊόντα. Μέχρι τον Ιούνιο 2024, είχαν εγκριθεί 201 μελέτες φαρμάκων και 20 ιατροτεχνολογικών προϊόντων.
«Τα στοιχεία αυτά είναι ενθαρρυντικά ως προς το ενδιαφέρον των διεθνών χορηγών να εντάξουν την χώρα μας στο ευρωπαϊκό τους πλάνο επενδύσεων», σημείωσε η κ. Κοράκη.
Εξήγησε στη συνέχεια ότι το βασικό εργαλείο του νέου Κανονισμού είναι το Πληροφοριακό Σύστημα Κλινικών Δοκιμών (CTIS), το οποίο αποτελεί και το μοναδικό σημείο εισόδου για την υποβολή όλων των νέων αιτήσεων κλινικών δοκιμών. Πλέον, οι χορηγοί μπορούν να υποβάλουν μία ηλεκτρονική αίτηση μέσω του CTIS για έγκριση διεξαγωγής κλινικών δοκιμών ταυτόχρονα σε πολλές Ευρωπαϊκές χώρες, καθιστώντας πιο αποτελεσματική τη διεξαγωγή τέτοιων πολυεθνικών δοκιμών.
Πρόσθετα έσοδα στα νοσοκομεία
Αναφερόμενοι οι εκπρόσωποι του HACRO στην πρόσφατη νομοθεσία, τόνισαν ότι σημαντική ώθηση μπορούν να δώσουν οι διατάξεις για το επενδυτικό Clawback και τον συμψηφισμό του με δαπάνες έρευνας, ρύθμιση για δυνατότητα των νοσοκομείων να έχουν έσοδα επιπλέον της κρατικής χρηματοδότησης από τη διεξαγωγή έρευνας στους χώρους του, καθώς και η ρύθμιση για τη δυνατότητα δημιουργίας τμήματος κλινικών μελετών στα νοσοκομεία του ΕΣΥ.
Προς την ίδια κατεύθυνση, στα επόμενα βήματα θα πρέπει να περιλαμβάνονται κατά προτεραιότητα: η επίλυση θεμάτων νομοθετικού περιεχομένου, η υλοποίηση του «Εθνικού Μητρώου Βιοϊατρικής Έρευνας», η υλοποίηση εκπαιδευτικών δράσεων, η βελτίωση των προϋποθέσεων συμψηφισμού του επενδυτικού Clawback, η ενίσχυση των οικονομικών κίνητρων για τις φαρμακευτικές εταιρίες που δραστηριοποιούνται στην Ελλάδα, η ενίσχυση των επενδυτικών κινήτρων για τις φαρμακευτικές εταιρείες που δεν έχουν παρουσία στην Ελλάδα, καθώς και η στελέχωση του Εθνικού Οργανισμού Φαρμάκων και της Εθνικής Επιτροπής Δεοντολογίας με επαρκές και κατάλληλα εκπαιδευμένο προσωπικό.
Κριτήρια προσέλκυσης επενδυτικών κεφαλαίων
Όπως τονίσθηκε στη συνάντηση, ο κλάδος των κλινικών μελετών είναι ιδιαίτερα ανταγωνιστικός.
Η χώρα μας συγκρίνεται σε όλα τα επίπεδα με τα υπόλοιπα κράτη μέλη της Ευρώπης στα κριτήρια προσέλκυσης των διαθέσιμων επενδυτικών κεφαλαίων.
Σύμφωνα με πρόσφατες έρευνες που έχουν διεξαχθεί από τις εταιρείες PwC, IQVIA και το ΙΟΒΕ, τα κυριότερα κριτήρια προσέλκυσης επενδύσεων αφορούν την ταχύτητα διεξαγωγής, τα ποιοτικά κριτήρια όπως η εμπειρία, η τεχνογνωσία, η συνέπεια, οι υποδομές και η σταθερότητα και τα οικονομικά κίνητρα.
Τα ίδια κριτήρια επιβεβαιώνουν στην καθημερινή τους πρακτική οι εταιρείες CRO που αναλαμβάνουν εκ μέρους των χορηγών, διεθνών φαρμακευτικών εταιρειών, τη διερεύνηση του περιβάλλοντος για την διεξαγωγή κλινικών μελετών στη χώρα. Τα ποιοτικά κριτήρια και η ταχύτητα διεξαγωγής καθώς και εύρεσης και προσέλκυσης ασθενών στις μελέτες είναι σαφές πως αποτελούν κρίσιμους παράγοντες που μπορεί να ενθαρρύνουν ή να αποτρέψουν τη διεξαγωγή μελετών στην Ελλάδα. Εφόσον βελτιώσουμε τις επιδόσεις μας ως χώρα σε αυτά τα κριτήρια θα μπορέσουμε να ανεβάσουμε την κατά κεφαλή επένδυση σε κλινικές μελέτες από το τωρινό εκτιμώμενο 10% του Ευρωπαϊκού μέσου όρου επένδυσης.
Σύμφωνα με τα παραπάνω ποσοστά και με βάση το μέγεθος και τον πληθυσμό της χώρας μας να αντιστοιχεί στο 1,5% της Ευρώπης, μπορούμε να προσελκύσουμε επενδύσεις πάνω από €500 εκ. σε ετήσια βάση, και να επιτύχουμε σημαντική αύξηση του ΑΕΠ και τη δημιουργία χιλιάδων νέων θέσεων εργασίας. Συγκεκριμένα, η προσέλκυση 0,5 δις επενδύσεων σε κλινική έρευνα θα οδηγούσε σε:
- 1,1 δις αύξηση του ΑΕΠ,
- 270 εκ έσοδα από φόρους
- 23.000 νέες θέσεις εργασίας υψηλού επιπέδου όπως γιατροί, νοσηλευτές, λοιπό επιστημονικό προσωπικό και ανάλογη μείωση της ανεργίας